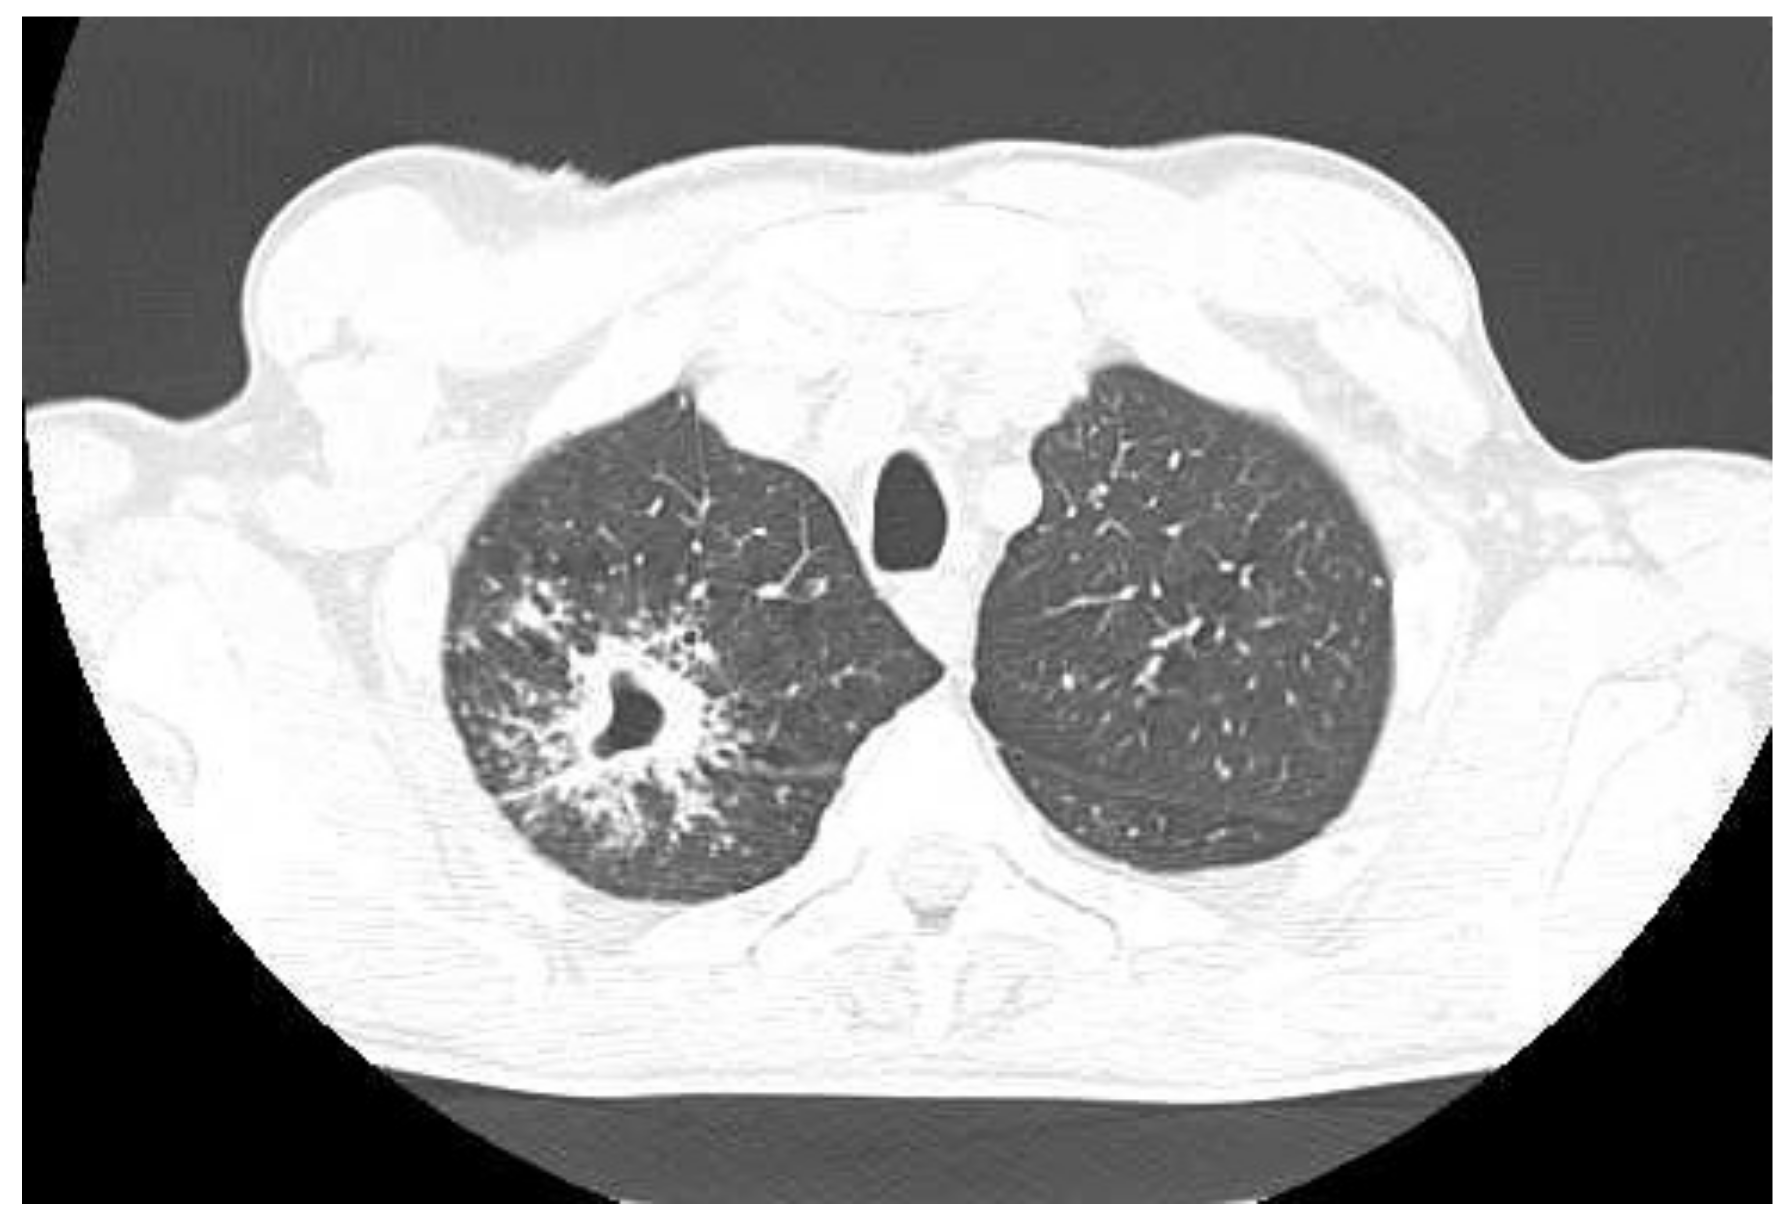

マイストア
変更
お店で受け取る
(送料無料)
配送する
納期目安:
2025.09.03 15:3頃のお届け予定です。
決済方法が、クレジット、代金引換の場合に限ります。その他の決済方法の場合はこちらをご確認ください。
※土・日・祝日の注文の場合や在庫状況によって、商品のお届けにお時間をいただく場合がございます。
健康・医学 Tuberculosis LA County Department of Public Healthの詳細情報
LA County Department of Public Health。Tuberculosis Control Unit | County of Monterey, CA。LA County Department of Public Health。William N. Rom 他1名1996年発行大型洋書1001pThis comprehensive clinical reference is edited by experts from the NYU-Bellevue Chest Service, which through its influence in tuberculosis care and education has been an integral part of the formation of the entire specialty of pulmonary medicine. The book draws on this extensive experience to present an authoritative account of the history, epidemiology, microbiology, immunology, clinical treatment, pharmacology, and prevention or control of tuberculosis. The book will serve as a definitive reference for specialists in pulmonary medicine, infectious disease, and public health. 裁断面にやや汚れあります。Infections in Endocrinology: Tuberculosis - Endotext - NCBI。11p程にハイライトされた箇所ありますが、本文には書き込みも傷も汚れもなく、良好な状態です。。ご購入の際、念の為、一度在庫確認させて頂きたく存じます。イヤーノート 4冊セット 2016年。どうぞ宜しくお願い致します。内科専門医問題集。
ベストセラーランキングです
近くの売り場の商品
カスタマーレビュー
オススメ度 4.8点
現在、4448件のレビューが投稿されています。